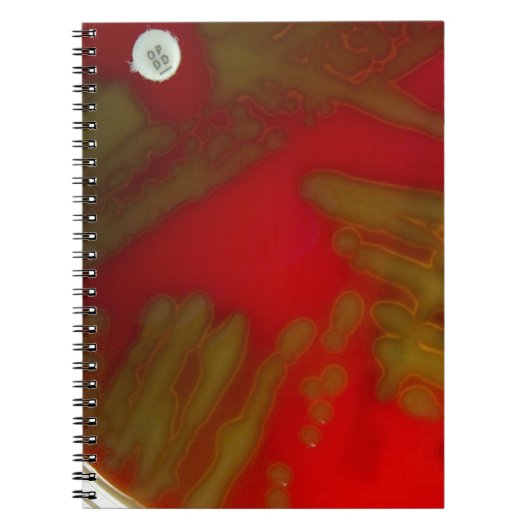
Penumoniaの細菌 ノートブック (正面)

ノートブックについて
販売:
このデザインについて
Penumoniaの細菌 ノートブック
それに置かれるoptochin抗生ディスクが付いている連鎖球菌pneumoniaeの縞のプレート。 プレートは血液寒天培地のプレートのアルファhemoloysisを示します。
自動翻訳
カスタマーレビュー
5つ星評価のうち星5.0全レビュー数 1
レビュー:1
類似商品のレビュー
5つ星評価のうち星5
e.2015年9月11日 • 認証済みのご注文
フォトノートブック (約16.5cm × 22.2cm / 80ページ 白黒 )
Zazzleレビュープログラム
主人が、リフレクソロジーの資格を取得した記念にと注文しました。
ノートの表紙だけでも、ツボの勉強ができるので
素敵&役立ちすぎます。ノートでした。紙質も上品でしっかりしていました。
最高のプレゼントになりました。。
本当にありがとうございました。 しっかりとした印刷です。、細かい足裏のツボや、下の小さい文字も、きっちりと読めるほどに
素晴らしいと思いました。本当に Zazzleさんの商品は、どれも素晴らしいので
超オススメです。
タグ
その他の情報
商品 ID: 130262507079714533
出品日: 2013/12/24 8:42
レーティング: G
最近閲覧された商品